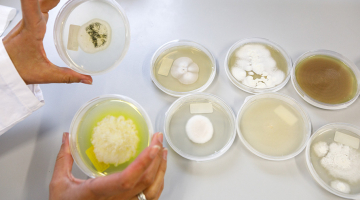

Waardevolle micro-organismen ‘oogsten’ uit laagwaardige biomassa
De Vlaamse biotech startup Zymofix zet biomassareststromen (bijvoorbeeld agrarische reststromen) om in nuttige micro-organismen. Die zijn heel waardevol voor de verbetering van de bodemgezondheid, de afbraak van vervuilende stoffen of de vervanging van traditionele chemische processen in verschillende industrieën. Het bedrijf is bezig aan een mooi groeiparcours en haalde naast de steun die het van VLAIO ontving recent nog twee miljoen euro kapitaal op voor het schalen van haar innovatieve fermentatietechnologie.
Ecosystemen herstellen
“Wat Zymofix wil, is de productie van micro-organismen toegankelijk en betaalbaar maken door een alternatieve productietechnologie aan te bieden”, aldus CEO Emile Redant. “Vandaag gebeurt die productie hoofdzakelijk in bioreactoren, vergelijkbaar met hoe bier wordt gebrouwen, of via vaste fermentatie op substraten als rijst. Dat zijn technologieën die vrij duur uitvallen. Wat wij doen, is laagwaardige, goedkope en lokaal beschikbare biomassa (zoals digestaat, plantenresten en mest) via restwarmte thermisch verwerken en als grondstof gebruiken om organismen te laten groeien. Zo valoriseren wij niet alleen deze biomassa, maar bieden we ook een oplossing voor de overschotten aan laagwaardig materiaal. Bovendien verlagen we de productiekosten voor deze microbiële producten aanzienlijk, omdat we met lokaal beschikbare biomassa werken.”
Emile: “we focussen op de landbouw, waarbij onze micro-organismen de groei van planten stimuleren of planten beschermen tegen bepaalde stress. We spreken dan over gewassen als maïs, tarwe en suikerbiet. Maar op termijn zien we ook mogelijkheden met microorganismen in bijvoorbeeld afvalverwerking, bioremediatie en andere industrieën. Dat moet lukken, ten eerste omdat onze innovatieve technologie veelzijdig, schaalbaar en lokaal toepasbaar is, en op die manier op maat gemaakte oplossingen biedt. En ten tweede omdat we – onder meer dankzij sterke banden met VIB – een stevige basis in de industriële biotechnologie hebben. Ruimer gesteld zou je kunnen zeggen dat het de ambitie van Zymofix is om afval om te zetten naar waardevolle grondstoffen die ecosystemen helpen herstellen.”
De micro-organismen die N-Fix (nu Zymofix) gaat opkweken, dragen bij aan duurzame voedselproductie en bodemgebruik : ze beperken het gebruik van agrochemicaliën, verlagen het verlies aan nutriënten en herstellen de bodembiodiversiteit.

Risico’s indijken
Emile: “De eerste grote uitdaging waar we voor staan, is het verder opschalen van onze technologie. We hebben in ons labo en met onze pilootinstallatie aangetoond dat het werkt, maar nu moeten we verder opschalen en een eerste fabriek bouwen. Alleen: als je groter gaat, duiken er altijd onverwachte neveneffecten op, zoals warmteoverdracht, contaminatie, verstoppingen … Recent haalden we twee miljoen euro op om die risico’s in te dijken. Die investeringsronde moet ons toelaten onze innovatieve en duurzame fermentatietechnologie verder te commercialiseren.”
“De tweede uitdaging is dat we afnemers nodig hebben: als we een fabriek plaatsen, moet er natuurlijk ook een verder afgelijndeproduct-market fit zijn. En daarvoor hebben we wetenschappelijke data nodig die aantonen dat ons product minstens evenwaardig is aan bestaande producten in de markt.”

De verschillende subsidies hebben ons geholpen om te overleven. Zeker omdat vorig jaar een redelijk lastige investeringsperiode was.
Veel extra middelen
Nog voor die twee miljoen euro investeringskapitaal in beeld kwam, kon Zymofix al rekenen op de nodige ondersteuning, onder meer van VLAIO. Dat was broodnodig, omdat de biotech start-up geen spin-off van een wetenschappelijke instelling is en dus letterlijk van een wit blad start. Emile: “Bij VLAIO kregen we steun voor een haalbaarheidsstudie, waarmee we een eerste proof of concept ontwikkelden. Dat heeft geleid tot een ontwikkelingsproject én liet ons tegelijkertijd toe de EIC Accelerator Grant binnen te halen, een Europees instrument dat bedrijven met marktgerichte innovaties en veel groeipotentieel ondersteunt. Dat was ook goed voor 2,5 miljoen euro.”
“Die financiële ondersteuning heeft ons niet alleen veel extra middelen gegeven om onze technologie te derisken, maar ook simpelweg om te overleven. Zeker omdat vorig jaar toch een redelijk lastige investeringsperiode was. Deinhoud van deze onderzoeksprojecten komt 1-op-1 overeen met de bedrijfsroadmap die we voor ogen hebben. Hierdoor worden mensen en middelen heel efficiënt gealloceerd, wat de slagkracht en impact van de steun aanzienlijk vergroot.””

Vuur aan de schenen
Financiële ondersteuning is één ding, maar als start-up moet je wel van het bestaan van die hefbomen afweten en vervolgens ook over de kennis en kunde beschikken om die aan te vragen. Ook daarin bleek VLAIO een waardevolle partner. Emile: “Toen we startten, werden wij meteen geselecteerd voor het biotope incubatorprogramma van VIB. Van daaruit zijn wij in contact gekomen met VLAIO bedrijfsadviseur Katelijne Strubbe. In die beginfase zat ze meermaals met ons samen om te kijken welke steun wanneer het best bij ons paste. Vervolgens bracht ze ons ook via het Enterprise Europe Network (EEN) en het National Contact Point (NCP Flanders) in contact met andere bedrijven, wat leidde tot de Europese steun die ik eerder vermeldde. Let wel, die EIC Accelerator Grant hebben we zelf opgezocht en binnengehaald, maar VLAIO heeft ons – in samenwerking met FIT (Flanders Investment & Trade) – geholpen door twee pittige oefensessies te organiseren, om ons voor te bereiden op de intense interviews, waar ons toch behoorlijk het vuur aan de schenen werd gelegd. Laten we zeggen dat die oefensessies confronterend waren, maar dan op een goeie manier (lacht).”

Duurzame landbouw
“We werven momenteel een CTO aan”, beantwoordt Emile Redant de vraag naar de ambities van Zymofix. “En in Vlaanderen de eerste commerciële fabriek bouwen die bijdraagt aan duurzame landbouw door micro-organismen uit laagwaardige biomassa te halen, lijkt me een stevige ambitie. De bedoeling is dat we binnenkort weer met VLAIO in gesprek gaan om beter te begrijpen welke Vlaamse steun daarvoor mogelijk is. Kortom, de samenwerking met VLAIO is nog lang niet afgelopen. Meer nog, zelfs bij het scouten naar locaties voor onze fabriek hebben zij ons waardevol advies gegeven.”
